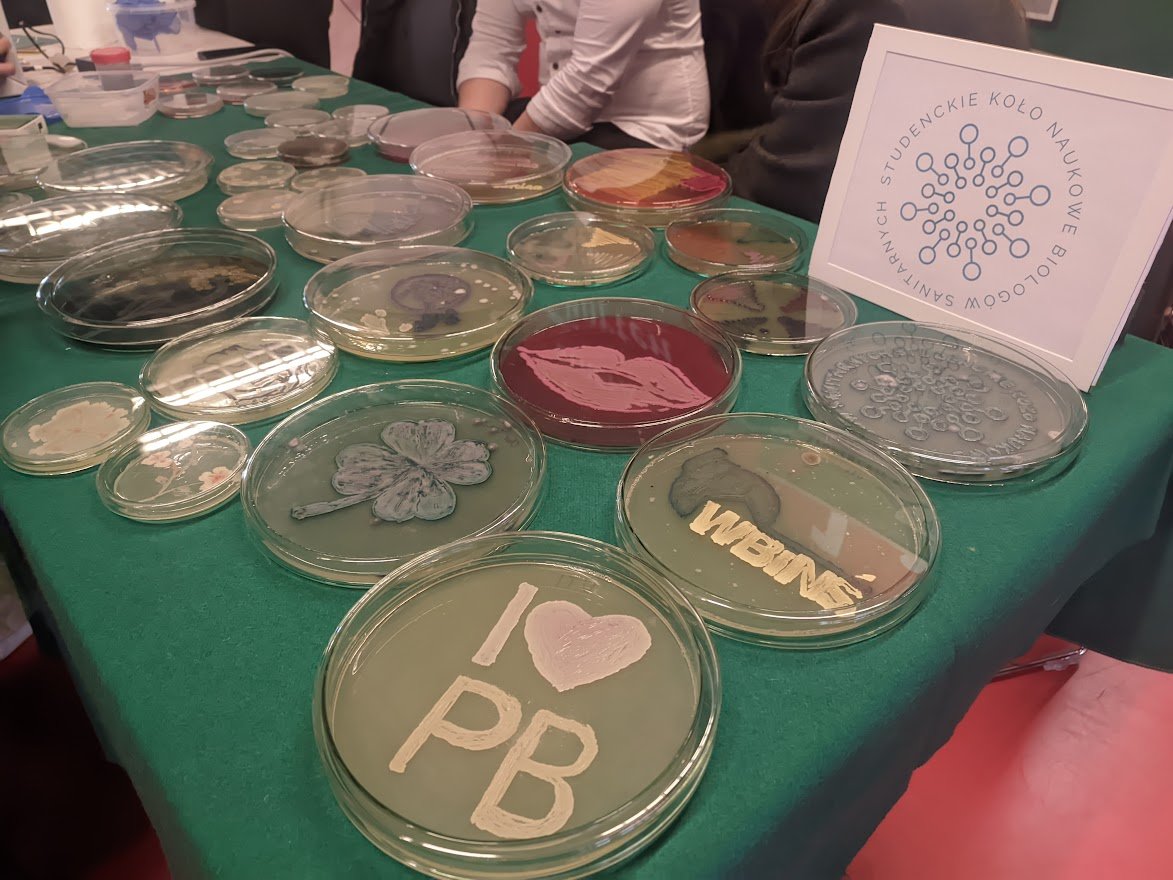

Rodzinny Piknik Naukowy, fot. Hanna Kość
Rodzinny Piknik Naukowy, fot. Hanna Kość
Moc atrakcji dla miłośników nauk technicznych, humanistycznych, medycznych i artystycznych było na Rodzinnym Pikniku Naukowym. Tym wydarzeniem zakończył się Podlaski Festiwal Nauki i Sztuki, w którym podlaskie uczelnie w sumie zaprezentowały 500 wydarzeń naukowych.
Tegorocznym hasłem przewodnim były słowa odkrywcy penicyliny Aleksandra Fleminga: „Nie lekceważcie nigdy zjawisk, które wydają wam się niezwykłe”.
– Mi się podobało, jak patrzyłam przez szkiełko i są tam różne wirusy i bakterie. Dużo ciekawych rzeczy. To jest taka maszyna, taki potencjometr, że można zmieniać szybkość, ciśnienie. To mnie interesuje. Takie wydarzenie poszerzają horyzonty u dzieci, ale oczywiście dorośli też poznają i też się rozwijają. Tutaj programuję robota, to fajna zabawa. Pokazujemy tak naprawdę jak robotyka otacza nas w dniu codziennym i pokazujemy najmłodszym, że nie jest to wcale takie straszne, a może być przyjemne – mówią uczestnicy Rodzinnego Pikniku Naukowego.
Piknik naukowy, jak i całe Festiwal Nauki i Sztuki popularyzuje naukę, którą zajmują się podlaskie uczelnie. Na Rodzinnym Pikniku Naukowym nie zabrakło też stosik Politechniki Białostockiej, gdzie studenci prezentowali swoje osiągnięcia techniczne i inspirowali do odkrywania nauki.
– Nauka i sztuka jest zdecydowanie dla wszystkich, a oferta, którą przygotowują uczelnie, w tym Politechnika Białostocka, też skierowana jest do odbiorców od lat 3 do 103 – mówi prof. Marta Kosior-Kazberuk, rektor Politechniki Białostockiej.
Tegorocznym koordynatorem głównym Festiwalu Nauki i Sztuki był Uniwersytet Medyczny w Białymstoku. – Nauka przenika nas, ona jest z nami, ona towarzyszy nam w codziennym życiu, więc zamiast dać się jej kierować, pozwólmy sami kierować badaniami naukowymi. Wejdźmy w ten świat, przeżyjmy tę piękną przygodę. O tym jest ten piknik, o tym jest ten festiwal – dodaje prof. Marcin Moniuszko, rektor Uniwersytetu Medycznego w Białymstoku.
W ramach Rodzinnego Pikniku Naukowego były eksperymenty, pokazy i warsztaty oraz koncerty i wystawy. (hk)
Relacja Hanny Kość: